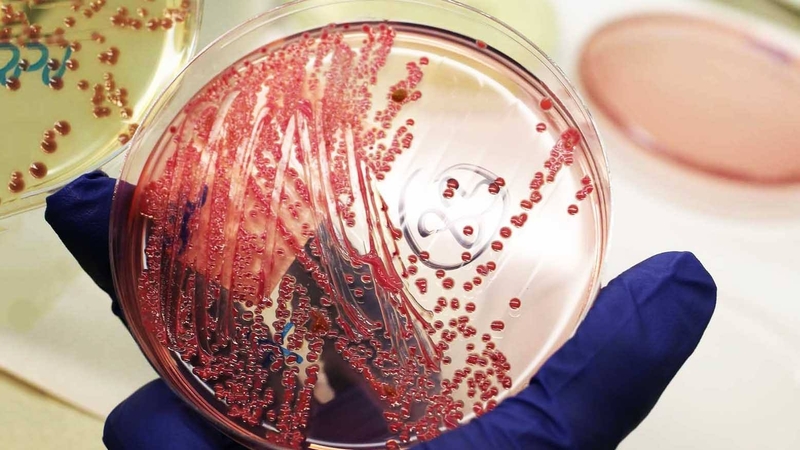
Hiểu về xét nghiệm cấy máu trong nhiễm khuẩn huyết 1

Tốt nghiệp Khoa Dược trường Đại học Nam Cần Thơ. Có nhiều năm kinh nghiệm công tác trong lĩnh vực Dược phẩm. Hiện đang giảng viên cho Dược sĩ tại Nhà thuốc Long Châu.
Tố Uyên
05/04/2024
Mặc định
Lớn hơn
Nhiễm trùng huyết là tình trạng nghiêm trọng vì máu có thể lây lan vi khuẩn đến bất kỳ bộ phận nào của cơ thể, thường xảy ra cùng với các bệnh nhiễm trùng nghiêm trọng khác gây ảnh hưởng đến phổi, thận, ruột, hoặc van tim. Lúc này, cấy máu trong nhiễm khuẩn huyết giúp phát hiện ổ vi khuẩn và có phương án điều trị phù hợp.
Trong máu của người khỏe mạnh thường không có vi khuẩn hoặc nấm trong đó. Cấy máu trong nhiễm khuẩn huyết là phương pháp xét nghiệm mẫu máu để tìm vi khuẩn hoặc nấm trong máu.
Cấy máu trong nhiễm khuẩn huyết là xét nghiệm kiểm tra những tác nhân gây nhiễm trùng như vi khuẩn, nấm men và các vi sinh vật khác trong máu của người bệnh. Sự xuất hiện của những tác nhân này trong máu có thể là dấu hiệu của tình trạng nhiễm khuẩn huyết. Kết quả cấy máu dương tính có nghĩa là trong máu của người bệnh có vi khuẩn tồn tại.
Mục đích của xét nghiệm cấy máu trong nhiễm khuẩn huyết là giúp bác sĩ tìm ra loại vi khuẩn hoặc nấm gây ra nhiễm trùng. Từ đó, bác sĩ có thể tìm được ổ nhiễm trùng tiên phát từ một bộ phận nào đó như viêm phổi, viêm đường tiết niệu, viêm màng não,… Tìm được ổ nhiễm trùng đầu tiên giúp bác sĩ có phác đồ điều trị phù hợp và hiệu quả hơn.
Ngoài ra, xét nghiệm cấy máu còn giúp chẩn đoán tình trạng sốt không rõ nguyên nhân, tìm được loại kháng sinh đặc hiệu với chủng vi khuẩn hay theo dõi tiến triển của tình trạng nhiễm khuẩn trong suốt quá trình điều trị.
Để thực hiện được cấy máu trong nhiễm khuẩn huyết, bác sĩ cần lấy mẫu máu của người bệnh để thực hiện. Thời điểm lấy máu tốt nhất là lúc bệnh nhân đang lên cơn sốt và trước khi người bệnh sử dụng kháng sinh toàn thân. Tuy nhiên, trong trường hợp nguy kịch và cần mẫu máu để thực hiện xét nghiệm khẩn cấp thì vẫn có thể lấy máu khi bệnh nhân đã sử dụng kháng sinh.
Một số lưu ý khi lấy máu làm xét nghiệm:
Sau khi mẫu máu được chuyển đến phòng thí nghiệm, kỹ thuật viên sẽ đánh giá và kiểm tra mẫu. Nếu máu có những biểu hiện bất thường như có cặn, vẩn đục,… sẽ bị loại bỏ và cần tiến hành lấy lại.
Đối với mẫu đạt tiêu chuẩn sẽ được sử dụng cấy trong môi trường vô khuẩn để tìm tác nhân gây nhiễm trùng.

Với mẫu máu đạt chuẩn, kỹ thuật viên sẽ tiến hành nuôi cấy vi khuẩn. Bình cấy máu sẽ được đem đi ủ ấm trong điều kiện nhiệt độ từ 35 - 37 độ C trong thời gian từ 1 - 7 ngày. Bình cấy máu sẽ được quan sát hằng ngày, nếu trong máu có vi sinh vật sẽ làm thay đổi môi trường canh thang và có thể quan sát được bằng mắt thường. Sự thay đổi trong bình canh thang giúp đánh giá được loại vi sinh vật có trong máu:
Sau đó, tiếp tục làm tiêu bản nhuộm Gram âm và cấy lên môi trường thạch với các chai cấy máu có kết quả dương tính để xác định chi và loài của mầm bệnh thông qua kết quả nhuộm và hình thái của lạc khuẩn. Dựa vào kết quả định danh để lên kháng sinh đồ phù hợp với mỗi bệnh nhân.

Nếu hai hoặc nhiều mẫu cấy máu của người bệnh dương tính với cùng một loại vi khuẩn hoặc nấm thì loại nấm hay vi khuẩn này chính là loại vi sinh vật gây ra nhiễm trùng. Bác sĩ sẽ dựa vào định danh của vi sinh vật để đưa ra loại kháng sinh phù hợp trong điều trị.
Nếu chỉ có 1 mẫu máu dương tính và những mẫu máu còn lại âm tính, người bệnh cũng có thể bị nhiễm trùng huyết. Nhưng cũng có thể mẫu máu của người bệnh bị nhiễm vi khuẩn trên da của họ trong quá trình lấy máu. Với trường hợp này, bác sĩ sẽ yêu cầu thực hiện xét nghiệm bổ sung để chắc chắn chẩn đoán.
Nếu tất cả các xét nghiệm cấy máu trong nhiễm khuẩn huyết đều âm tính, thì có thể bạn không bị nhiễm trùng máu. Nếu các triệu chứng nhiễm trùng lâm sàng của người bệnh vẫn tồn tại, bác sĩ sẽ xem xét lại và bổ sung thêm các chẩn đoán và xét nghiệm hỗ trợ để tìm hiểu rõ nguyên nhân.
Một điều lưu ý quan trọng là cấy máu trong nhiễm khuẩn huyết không thể phát hiện nhiễm virus mà chỉ phát hiện được nấm hoặc vi khuẩn. Nếu bác sĩ nghi ngờ bạn bị nhiễm virus, họ sẽ yêu cầu thực hiện các xét nghiệm thích hợp khác.
Như vậy, tùy thuộc vào loại vi khuẩn, nấm được phát hiện trong quá trình cấy máu, bác sĩ sẽ thực hiện các xét nghiệm độ nhạy bổ sung. Thử nghiệm này xác định các loại thuốc cụ thể có hiệu quả chống lại vi khuẩn, nấm. Trong xét nghiệm cận lâm sàng, xét nghiệm độ nhạy được thực hiện ngay sau khi xét nghiệm cấy máu trong nhiễm khuẩn huyết có kết quả dương tính.

Mặc dù cấy máu trong nhiễm khuẩn huyết là xét nghiệm tối ưu nhất hiện nay để tìm ra nguyên nhân gây nhiễm trùng trong máu nhưng không phải lúc nào xét nghiệm này cũng thực hiện thành công. Một số nguyên nhân gây ra bao gồm:
Cấy máu trong nhiễm khuẩn huyết là phương pháp xét nghiệm giúp tìm các vi sinh vật gây nhiễm trùng và từ đó có phác đồ điều trị phù hợp. Phương pháp này cần được thực hiện đúng theo quy trình để có kết quả chính xác nhất. Chỉ một sai sót nhỏ trong quá trình lấy mẫu hoặc nuôi cấy cũng có thể khiến kết quả thiếu chính xác, ảnh hưởng đến việc điều trị kịp thời cho người bệnh.
Xem thêm:
Dấu hiệu và những nơi cục máu đông có thể hình thành
Rối loạn đông máu là gì? Những điều cần biết về rối loạn đông máu
Dược sĩ Đại họcNguyễn Thị Thảo Nguyên
Tốt nghiệp Khoa Dược trường Đại học Nam Cần Thơ. Có nhiều năm kinh nghiệm công tác trong lĩnh vực Dược phẩm. Hiện đang giảng viên cho Dược sĩ tại Nhà thuốc Long Châu.